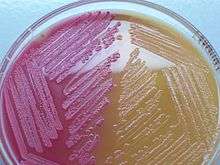

MacConkey agar

MacConkey agar is a selective and differential culture medium for bacteria designed to selectively isolate Gram-negative and enteric (normally found in the intestinal tract) bacilli and differentiate them based on lactose fermentation.[1] The crystal violet and bile salts inhibit the growth of gram-positive organisms which allows for the selection and isolation of gram-negative bacteria. Enteric bacteria that have the ability to ferment lactose can be detected using the carbohydrate lactose, and the pH indicator neutral red.[2]
Contents
It contains bile salts (to inhibit most Gram-positive bacteria), crystal violet dye (which also inhibits certain Gram-positive bacteria), neutral red dye (which turns pink if the microbes are fermenting lactose).
Composition:[3]
- Peptone – 17 g
- Proteose peptone – 3 g
- Lactose – 10 g
- Bile salts – 1.5 g
- Sodium chloride – 5 g
- Neutral red – 0.03 g
- Crystal violet – 0.001 g
- Agar – 13.5 g
- Water – add to make 1 litre; adjust pH to 7.1 +/− 0.2
There are many variations of MacConkey agar depending on the need. If the spreading or swarming of Proteus species is not required, sodium chloride is omitted. Crystal violet at a concentration of 0.0001% (0.001 g per litre) is included when needing to check if Gram-positive bacteria are inhibited. MacConkey with sorbitol is used to isolate E. coli O157, an enteric pathogen.
History
The medium was developed by Alfred Theodore MacConkey while working as a bacteriologist for the Royal Commission on Sewage Disposal.
Uses
Using neutral red pH indicator, the agar distinguishes those Gram-negative bacteria that can ferment the sugar lactose (Lac+) from those that cannot (Lac-)fermentation.
This medium is also known as an "indicator medium" and a "low selective medium". Presence of bile salts inhibits swarming by Proteus species.
Lac+
By utilizing the lactose available in the medium, Lac+ bacteria such as Escherichia coli, Enterobacter and Klebsiella will produce acid, which lowers the pH of the agar below 6.8 and results in the appearance of pink colonies. The bile salts precipitate in the immediate neighbourhood of the colony, causing the medium surrounding the colony to become hazy.[4][5]
Lac-
Non-Lactose fermenting bacteria such as Salmonella, Proteus species, Yersinia, Pseudomonas aeruginosa and Shigella cannot utilize lactose, and will use peptone instead. This forms ammonia, which raises the pH of the agar, and leads to the formation of white/colorless colonies on the petri plate.
Slow
Some organisms ferment lactose slowly or weakly, and are sometimes put in their own category. These include Serratia[6] and Citrobacter.[7]
Mucoid colonies
Some organisms, especially Klebsiella and Enterobacter, produce mucoid colonies which appear very moist and sticky. This phenomenon happens because the organism is producing a capsule, which is predominantly made from the lactose sugar in the agar.
Variant
A variant, Sorbitol-MacConkey agar, (with the addition of additional selective agents) can assist in the isolation and differentiation of enterohaemorragic E. coli serotype E. coli O157:H7, by the presence of colourless circular colonies that are non-sorbitol fermenting.
See also
- R2a agar
- MRS agar (culture medium designed to grow Gram-positive bacteria and differentiate them for lactose fermentation).
References
- ↑ "tmc.edu".
- ↑ Anderson, Cindy (2013). Great Adventures in the Microbiology Laboratory (7th ed.). Pearson. pp. 175–176. ISBN 978-1-269-39068-2.
- ↑ http://www.microbelibrary.org/index.php/component/resource/laboratory-test/2855-macconkey-agar-plates-protocols
- ↑ MacConkey AT (1905). "Lactose-Fermenting Bacteria in Faeces.". J Hyg (Lond). 5 (3): 333–79. doi:10.1017/s002217240000259x. PMC 2236133
 . PMID 20474229.
. PMID 20474229. - ↑ MacConkey AT (1908). "Bile Salt Media and their advantages in some Bacteriological Examinations.". J Hyg (Lond). 8 (3): 322–34. doi:10.1017/s0022172400003375. PMC 2167122
 . PMID 20474363.
. PMID 20474363. - ↑ Luis M. De LA Maza; Pezzlo, Marie T.; Janet T. Shigei; Peterson, Ellena M. (2004). Color Atlas of Medical Bacteriology. Washington, D.C: ASM Press. p. 103. ISBN 1-55581-206-6.
- ↑ "Medmicro Chapter 26". Archived from the original on 2008-07-06. Retrieved 2008-12-11.
